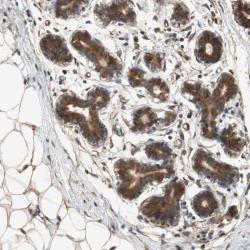

Antibody data
- Antibody Data
- Antigen structure
- References [21]
- Comments [0]
- Validations
- Western blot [1]
- Immunohistochemistry [1]
Submit
Validation data
Reference
Comment
Report error
- Product number
- sc-9104 - Provider product page

- Provider
- Santa Cruz Biotechnology
- Proper citation
- Santa Cruz Biotechnology Cat#sc-9104, RRID:AB_2241191
- Product name
- Anti-TUBB
- Antibody type
- Polyclonal
- Antigen
- Recombinant full-length protein
- Reactivity
- Human
- Host
- Rabbit
Submitted references Up-regulation of METCAM/MUC18 promotes motility, invasion, and tumorigenesis of human breast cancer cells.
Lack of a synergistic effect of a non-viral ALS gene therapy based on BDNF and a TTC fusion molecule.
Proteomic identification of protein targets for 15-deoxy-Δ(12,14)-prostaglandin J2 in neuronal plasma membrane.
Potential tumor suppressor role for the c-Myb oncogene in luminal breast cancer.
Elevated PIN1 expression by C/EBPalpha-p30 blocks C/EBPalpha-induced granulocytic differentiation through c-Jun in AML.
microRNA 17/20 inhibits cellular invasion and tumor metastasis in breast cancer by heterotypic signaling.
Histone acetyltransferase p300 is a coactivator for transcription factor REL and is C-terminally truncated in the human diffuse large B-cell lymphoma cell line RC-K8.
AP-1 (Fra-1/c-Jun)-mediated induction of expression of matrix metalloproteinase-2 is required for 15S-hydroxyeicosatetraenoic acid-induced angiogenesis.
Cyclin K and cyclin D1b are oncogenic in myeloma cells.
Requirement of the NF-kappaB subunit p65/RelA for K-Ras-induced lung tumorigenesis.
15(S)-hydroxyeicosatetraenoic acid-induced angiogenesis requires Src-mediated Egr-1-dependent rapid induction of FGF-2 expression.
Evaluation of LMP1 of Epstein-Barr virus as a therapeutic target by its inhibition.
Cyclin D1 is a bona fide target gene of NFATc1 and is sufficient in the mediation of injury-induced vascular wall remodeling.
Estrogen-mediated regulation of Igf1 transcription and uterine growth involves direct binding of estrogen receptor alpha to estrogen-responsive elements.
Characterization of an antagonistic switch between histone H3 lysine 27 methylation and acetylation in the transcriptional regulation of Polycomb group target genes.
Functional and cellular characterization of human Retinoic Acid Induced 1 (RAI1) mutations associated with Smith-Magenis Syndrome.
The novel mouse mutant, chuzhoi, has disruption of Ptk7 protein and exhibits defects in neural tube, heart and lung development and abnormal planar cell polarity in the ear.
The targeting of the sole cyclin D1 is not adequate for mantle cell lymphoma and myeloma therapies.
Negative regulation of the SH2-homology containing protein-tyrosine phosphatase-1 (SHP-1) P2 promoter by the HTLV-1 Tax oncoprotein.
Relevance of cyclin D1b expression and CCND1 polymorphism in the pathogenesis of multiple myeloma and mantle cell lymphoma.
The ubiquitin–protein ligase Itch regulates p73 stability
Zeng GF, Cai SX, Wu GJ
BMC cancer 2011 Mar 30;11:113
BMC cancer 2011 Mar 30;11:113
Lack of a synergistic effect of a non-viral ALS gene therapy based on BDNF and a TTC fusion molecule.
Calvo AC, Moreno-Igoa M, Mancuso R, Manzano R, Oliván S, Muñoz MJ, Penas C, Zaragoza P, Navarro X, Osta R
Orphanet journal of rare diseases 2011 Mar 21;6:10
Orphanet journal of rare diseases 2011 Mar 21;6:10
Proteomic identification of protein targets for 15-deoxy-Δ(12,14)-prostaglandin J2 in neuronal plasma membrane.
Yamamoto Y, Takase K, Kishino J, Fujita M, Okamura N, Sakaeda T, Fujimoto M, Yagami T
PloS one 2011 Mar 18;6(3):e17552
PloS one 2011 Mar 18;6(3):e17552
Potential tumor suppressor role for the c-Myb oncogene in luminal breast cancer.
Thorner AR, Parker JS, Hoadley KA, Perou CM
PloS one 2010 Oct 7;5(10):e13073
PloS one 2010 Oct 7;5(10):e13073
Elevated PIN1 expression by C/EBPalpha-p30 blocks C/EBPalpha-induced granulocytic differentiation through c-Jun in AML.
Pulikkan JA, Dengler V, Peer Zada AA, Kawasaki A, Geletu M, Pasalic Z, Bohlander SK, Ryo A, Tenen DG, Behre G
Leukemia : official journal of the Leukemia Society of America, Leukemia Research Fund, U.K 2010 May;24(5):914-23
Leukemia : official journal of the Leukemia Society of America, Leukemia Research Fund, U.K 2010 May;24(5):914-23
microRNA 17/20 inhibits cellular invasion and tumor metastasis in breast cancer by heterotypic signaling.
Yu Z, Willmarth NE, Zhou J, Katiyar S, Wang M, Liu Y, McCue PA, Quong AA, Lisanti MP, Pestell RG
Proceedings of the National Academy of Sciences of the United States of America 2010 May 4;107(18):8231-6
Proceedings of the National Academy of Sciences of the United States of America 2010 May 4;107(18):8231-6
Histone acetyltransferase p300 is a coactivator for transcription factor REL and is C-terminally truncated in the human diffuse large B-cell lymphoma cell line RC-K8.
Garbati MR, Alço G, Gilmore TD
Cancer letters 2010 May 28;291(2):237-45
Cancer letters 2010 May 28;291(2):237-45
AP-1 (Fra-1/c-Jun)-mediated induction of expression of matrix metalloproteinase-2 is required for 15S-hydroxyeicosatetraenoic acid-induced angiogenesis.
Singh NK, Quyen DV, Kundumani-Sridharan V, Brooks PC, Rao GN
The Journal of biological chemistry 2010 May 28;285(22):16830-43
The Journal of biological chemistry 2010 May 28;285(22):16830-43
Cyclin K and cyclin D1b are oncogenic in myeloma cells.
Marsaud V, Tchakarska G, Andrieux G, Liu JM, Dembele D, Jost B, Wdzieczak-Bakala J, Renoir JM, Sola B
Molecular cancer 2010 May 10;9:103
Molecular cancer 2010 May 10;9:103
Requirement of the NF-kappaB subunit p65/RelA for K-Ras-induced lung tumorigenesis.
Bassères DS, Ebbs A, Levantini E, Baldwin AS
Cancer research 2010 May 1;70(9):3537-46
Cancer research 2010 May 1;70(9):3537-46
15(S)-hydroxyeicosatetraenoic acid-induced angiogenesis requires Src-mediated Egr-1-dependent rapid induction of FGF-2 expression.
Kundumani-Sridharan V, Niu J, Wang D, Van Quyen D, Zhang Q, Singh NK, Subramani J, Karri S, Rao GN
Blood 2010 Mar 11;115(10):2105-16
Blood 2010 Mar 11;115(10):2105-16
Evaluation of LMP1 of Epstein-Barr virus as a therapeutic target by its inhibition.
Hannigan A, Wilson JB
Molecular cancer 2010 Jul 9;9:184
Molecular cancer 2010 Jul 9;9:184
Cyclin D1 is a bona fide target gene of NFATc1 and is sufficient in the mediation of injury-induced vascular wall remodeling.
Karpurapu M, Wang D, Van Quyen D, Kim TK, Kundumani-Sridharan V, Pulusani S, Rao GN
The Journal of biological chemistry 2010 Jan 29;285(5):3510-23
The Journal of biological chemistry 2010 Jan 29;285(5):3510-23
Estrogen-mediated regulation of Igf1 transcription and uterine growth involves direct binding of estrogen receptor alpha to estrogen-responsive elements.
Hewitt SC, Li Y, Li L, Korach KS
The Journal of biological chemistry 2010 Jan 22;285(4):2676-85
The Journal of biological chemistry 2010 Jan 22;285(4):2676-85
Characterization of an antagonistic switch between histone H3 lysine 27 methylation and acetylation in the transcriptional regulation of Polycomb group target genes.
Pasini D, Malatesta M, Jung HR, Walfridsson J, Willer A, Olsson L, Skotte J, Wutz A, Porse B, Jensen ON, Helin K
Nucleic acids research 2010 Aug;38(15):4958-69
Nucleic acids research 2010 Aug;38(15):4958-69
Functional and cellular characterization of human Retinoic Acid Induced 1 (RAI1) mutations associated with Smith-Magenis Syndrome.
Carmona-Mora P, Encina CA, Canales CP, Cao L, Molina J, Kairath P, Young JI, Walz K
BMC molecular biology 2010 Aug 25;11:63
BMC molecular biology 2010 Aug 25;11:63
The novel mouse mutant, chuzhoi, has disruption of Ptk7 protein and exhibits defects in neural tube, heart and lung development and abnormal planar cell polarity in the ear.
Paudyal A, Damrau C, Patterson VL, Ermakov A, Formstone C, Lalanne Z, Wells S, Lu X, Norris DP, Dean CH, Henderson DJ, Murdoch JN
BMC developmental biology 2010 Aug 12;10:87
BMC developmental biology 2010 Aug 12;10:87
The targeting of the sole cyclin D1 is not adequate for mantle cell lymphoma and myeloma therapies.
Tchakarska G, Le Lan-Leguen A, Roth L, Sola B
Haematologica 2009 Dec;94(12):1781-2
Haematologica 2009 Dec;94(12):1781-2
Negative regulation of the SH2-homology containing protein-tyrosine phosphatase-1 (SHP-1) P2 promoter by the HTLV-1 Tax oncoprotein.
Cheng J, Kydd AR, Nakase K, Noonan KM, Murakami A, Tao H, Dwyer M, Xu C, Zhu Q, Marasco WA
Blood 2007 Sep 15;110(6):2110-20
Blood 2007 Sep 15;110(6):2110-20
Relevance of cyclin D1b expression and CCND1 polymorphism in the pathogenesis of multiple myeloma and mantle cell lymphoma.
Krieger S, Gauduchon J, Roussel M, Troussard X, Sola B
BMC cancer 2006 Oct 6;6:238
BMC cancer 2006 Oct 6;6:238
The ubiquitin–protein ligase Itch regulates p73 stability
Mario Rossi, Vincenzo De Laurenzi, Eliana Munarriz, Douglas R Green, Yun-Cai Liu, Karen H Vousden, Gianni Cesareni, Gerry Melino
The EMBO Journal 2005 Jan;24(4):836-848
The EMBO Journal 2005 Jan;24(4):836-848
No comments: Submit comment
Supportive validation
- Submitted by
- per
- Main image

- Experimental details
- Western blot analysis of antibody specificity using a routine panel composed of IgG/HSA-depleted human plasma and protein lysates from selected human tissues and cell lines.
- Validation comment
- Band of predicted size in kDa (+/-20%) with additional bands present.
- Primary Ab dilution
- 1:500
- Secondary Ab dilution
- 1:3000
- Lane 1
- Marker [kDa]: 220, 112, 84, 47, 32, 26, 16.8
- Lane 2
- RT-4
- Lane 3
- U-251MG sp
- Lane 4
- Human Plasma
- Lane 5
- Liver
- Lane 6
- Tonsil
- Theoretical target weight
- [kDa] 42
Supportive validation
- Submitted by
- per
- Main image
- Experimental details
- Immunohistochemical staining of human breast shows strong cytoplasmic positivity in glandular cells.
- Validation comment
- Staining pattern consistent with experimental and/or bioinformatic data.